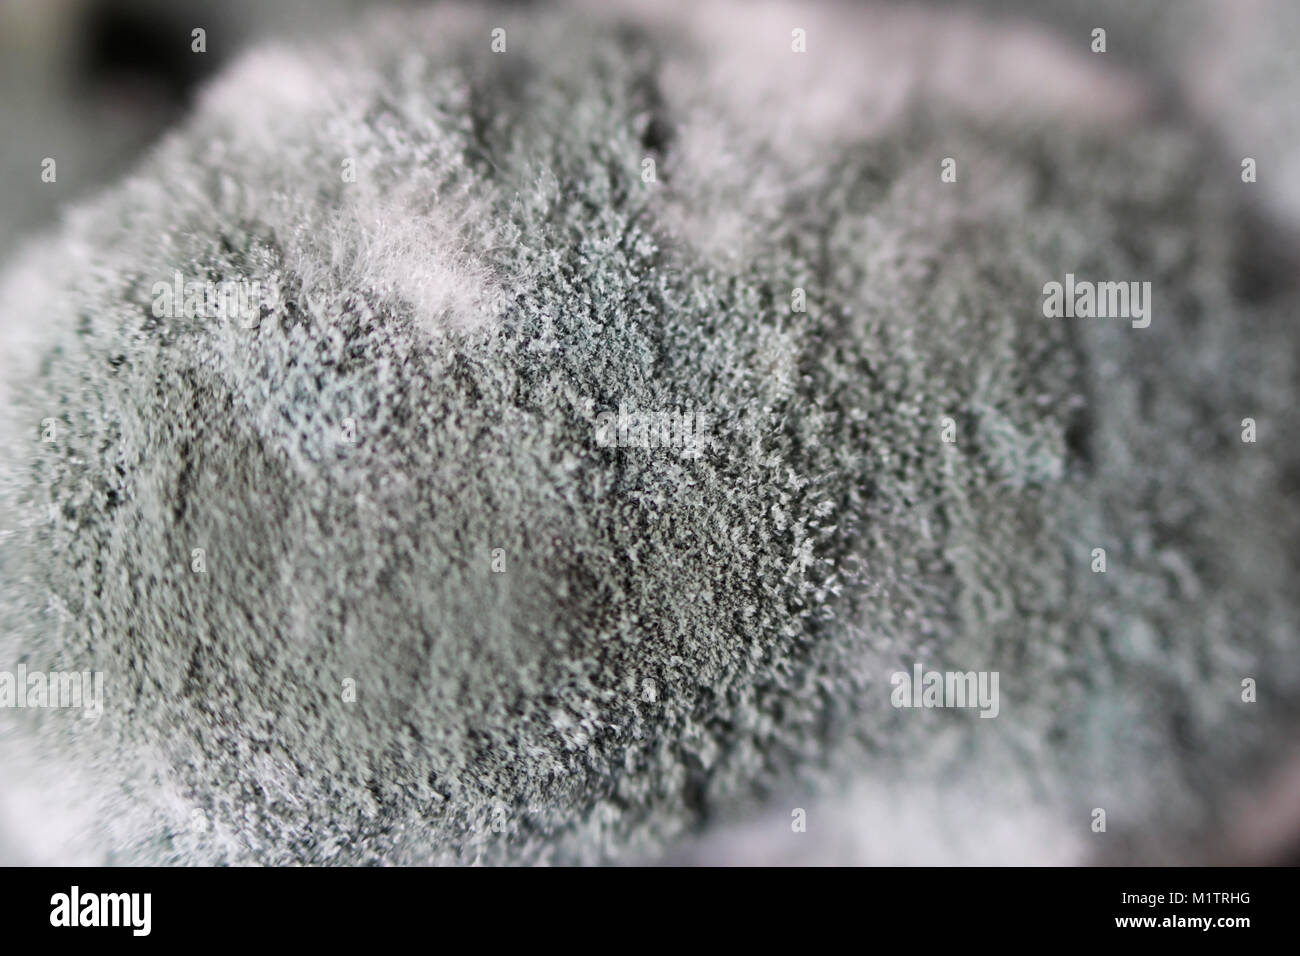
Aspergillus Banque du0027image et photos - Alamy

imunodéprimé aspergillus masque - Aspergillus Banque du0027image et photos - Alamy
Aspergillus Banque du0027image et photos - Alamy
Niccolou0027 Riccardi (@RiccardiNiccolo) / Twitter
PATHOLOGIE INFECTIEUSE - Abstract - Europe PMC
ASPERGILLUS ET POUMON: QUESTION Du0027ÉQUILIBRE u2013 BLOCKCHOC
HRCT Patterns SpringerLink
Aspergillus fumigatus images libres de droit, photos de 
Fièvre chez un patient immunodéprimé
ASPERGILLUS ET POUMON: QUESTION Du0027ÉQUILIBRE u2013 BLOCKCHOC
La mélanine de la paroi sporale du0027Aspergillus module le 
Aspergillose bronchopulmonaire allergique
Enzy-Peel Double-action Exfoliating Mask
Premium Photo White and blue tablets or pills or medication or drugs